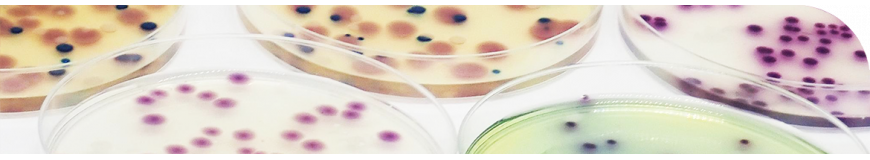
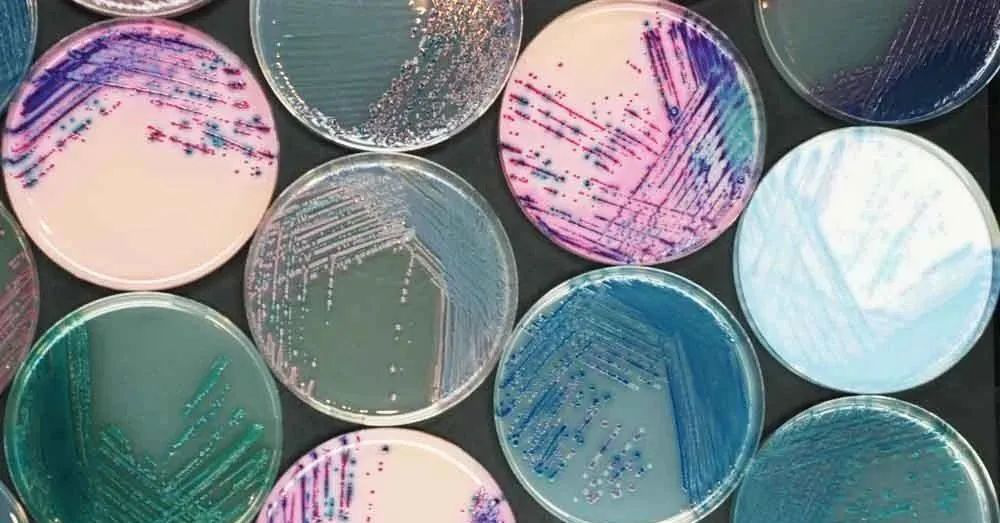

導航
導航
西班牙Condalab顯色培養基
Condalab顯色培養基
西班牙Condalab
Condalab成立于1960年,是西班牙第一家為微生物學(xué)和分子生物學(xué)制造的脫水培養基,也是世界領(lǐng)先的培養基之一,成立于西班牙的首都—馬德里。
Condalab因提供基礎瓊脂粉、蛋白胨、酵母粉和瓊脂糖等原料而聞名,出口全球120多個(gè)國家。在國際上,Condalab為行業(yè)公認的領(lǐng)軍機構,為用戶(hù)提供用于科研及生產(chǎn)使用的瓊脂、瓊脂糖、蛋白胨等關(guān)鍵原材料和產(chǎn)品。
Condalab的公司理念:成為為生命科學(xué)領(lǐng)域提供專(zhuān)業(yè)產(chǎn)品及高品質(zhì)服務(wù)的主要貢獻者。
分布Condalab的工廠(chǎng)位于西班牙馬德里郊區,產(chǎn)品出口全世界80多個(gè)國家,擁有多家分支機構和授權分銷(xiāo)商。專(zhuān)業(yè)的團隊是康達向所有客戶(hù)提供高質(zhì)量的產(chǎn)品和服務(wù)的信心保證。
Condalab多年來(lái)致力于生產(chǎn)國際一流水準的產(chǎn)品,Condalab的所有產(chǎn)品均符合ISO 9001:2000標準,并且于1998年成為西班牙首家獲得認證的公司。此外,康達的產(chǎn)品還符合國際上多項標準要求,包括ISO、歐洲藥典、FDA、APHA、USP和AOAC。
2003年11月公司獲得CE認證。質(zhì)控程序在整個(gè)產(chǎn)品生產(chǎn)過(guò)程中,Condalab公司采用嚴格的質(zhì)控程序,以保證產(chǎn)品高質(zhì)量及批次間的質(zhì)量一致。
Condalab顯色培養基優(yōu)勢:
1、短時(shí)間內得到初步檢驗結果,有效縮短檢驗時(shí)間
2、菌落明顯,易于觀(guān)察,外觀(guān)容易辨認,對檢測人員技術(shù)要求不高
3、酶與顯色底物顯色反應特異性強
4、檢出率高,假陽(yáng)性率低
5、減少后期鑒定工作量
河南海美迪生物技術(shù)有限公司
公司地址:河南省濮陽(yáng)縣鐵丘路路南中稹綠探院內3號樓
聯(lián)系電話(huà):13137349799
E-mail:[email protected]
河南利飛馳生物技術(shù)有限公司
公司地址:河南省濮陽(yáng)縣鐵丘路路南中稹綠探院內3號樓
聯(lián)系電話(huà):17310820029
E-mail:[email protected]
? 2021 河南海美迪生物技術(shù)有限公司 ALL Rights Reserved 備案號:豫ICP備2023018085號 技術(shù)支持:新網(wǎng)